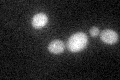
YJL204C
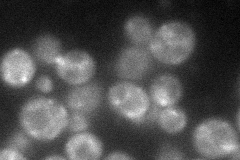
YJL204C
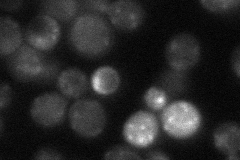
YJL204C
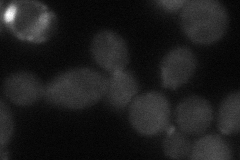
YJL204C
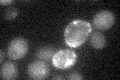
YJL204C

View description
F-box protein involved in recycling plasma membrane proteins internalized by endocytosis; localized to sites of polarized growth
Localization:
Intensity:
Fold change:
Significance:
-
C’ GFP library in SD
cytosol34.33 -
N' NOP1pr-GFP in SD
punctate,bud44.9522 -
N' TEF2pr-mCherry in SD

punctate,bud40.4882 -
N' NATIVEpr-GFP in SD
punctate26.4444 -
N' TEF2pr-VC and Cyto-VN in SD
cytosol,punctate40.3028 -
C’ GFP library in SD+DTT

cytosol27.660.8No -
C’ GFP library in SD+H2O2

cytosol18.640.54No -
C’ GFP library in Starvation Media
cytosol17.230.5No -
C’ GFP library on the background of Pup2-DaMP

cytosol -
C’ GFP library on the background of CCT mutant

cytosol24.0530.70051No
